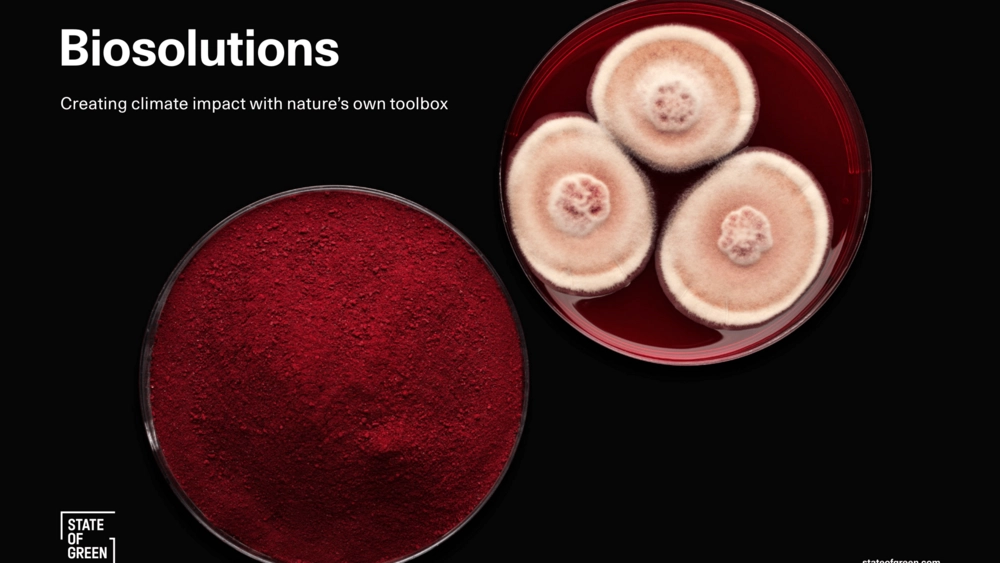
State of Green udgiver publikation om danske Biosolutions

22. april 2025
State of Green udgiver publikation om danske Biosolutions
Søger du og din arbejdsplads inspiration og kontakter til ledende virksomheder indenfor biosolution, herunder i forbindelse med udenlandske forretningskontakter, så er det en mulighed at studere State of Green’s nye publikation med gode eksempler på danske ledende virksomheder/institutioner.
Der indgår følgende elementer i publikationen:
- What are biosolutions?
- Denmark: the biosolutions centre of excellence
- Cases:
- Enablers
- Danish Technological Institute
- Biosolutions Zealand
- DTU Biosustain
- 21st.BIO
- Industry
- Novonesis
- Biomason
- Visibuilt
- Aquaporin
- Algiecel
- Bioli
- Food
- MATR
- FERM FOOD
- Arla Foods Ingredients
- FÆRM
- EvodiaBio
- Chromologics
- Enablers
Hent State of Green's publikation “Biosolutions. Creating climate impact with nature's own toolbox” fra 25. marts 2025 her